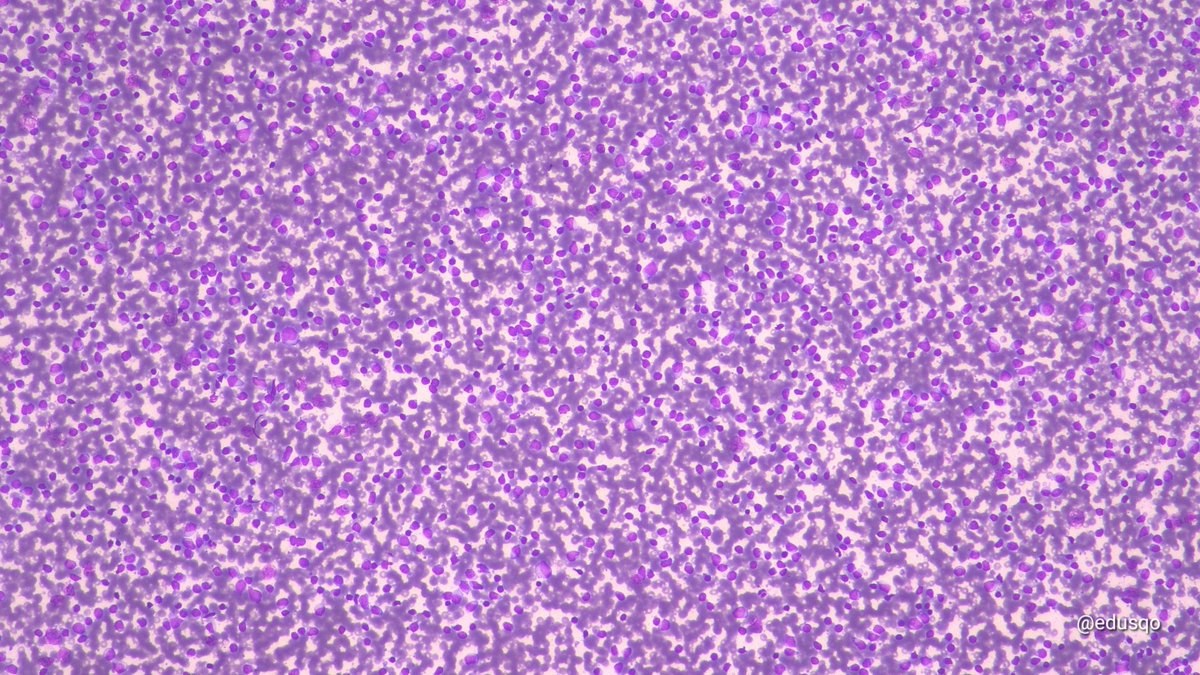
edusqo's tweet image. I love Cytospin for some #HemePath #CytoPath scenarios and even more when #IHCPath results are so usefull.
Small lymphocytic lymphoma. 
#IHCPath in the #CellBlock was also performed  #FNAFriday

Lara Pijuan,MD PhD,MIAC
@lara_pijuan
MD PhD MIAC #Cytopath, digital & #pulmpath #pathologist. Head of #Pathology Department at @HospitalSantPau #SoMe #DigitalPathology #cvpath #PathTwitter #PathX
You might like
My 3 favorites specialities in #pathology are #PulmPath #cytopath & #digitalpathology 😁



🔬📸 Pulmonary Hamartoma ~ 3 in 1... Cartilage (left), fat (white), and myxoid spindled cells (light blue) ~ #PulmPath #Pathology #PathArt

The myxoid spindle cells are key!
🔬📸 Pulmonary Hamartoma ~ 3 in 1... Cartilage (left), fat (white), and myxoid spindled cells (light blue) ~ #PulmPath #Pathology #PathArt

👙🎈💥🌋👩🏻🔧🔬Silicone breast implant rupture removal with reactive synovial metaplasia and giant cells reaction against silicone #breastpath #beautyinroutine #funinroutine #tuesdaymotivation



Tricomonas 💡En frotis muy inflamatorios, con vaginosis bacteriana o gardnerella, debes pensar en ellas 💡De forma aislada, pero en CBL más frecuentemente por encima de las células 💡Pequeñas, forma de almendra, citoplasma grisáceo, núcleo central alargado de color gris oscuro.




🟠 I'm very honoured to be part of this teaching initiative. 💪🏽 Empowering Pathologist. 👏🏽 Many thanks to Dr Fatma and the King Salman International University for the invitation. 💉 The Interventional Pathologist: Closer to the patient.



✅ Another advantage of being an Interventional Pathologist: The Patient knows who you are❗ Do we want visibility in Pathology ⁉️ 🫱🏽 What better way than to introduce ourselves when the patient comes to the Interventional Pathology office. 👇🏽 ICIP. January 28-29, 2026.


🏥El HUCA acogerá el 𝗖𝗼𝗻𝗴𝗿𝗲𝘀𝗼 𝗜𝗻𝘁𝗲𝗿𝗻𝗮𝗰𝗶𝗼𝗻𝗮𝗹 𝗱𝗲 𝗣𝗮𝘁𝗼𝗹𝗼𝗴𝗶́𝗮 𝗜𝗻𝘁𝗲𝗿𝘃𝗲𝗻𝗰𝗶𝗼𝗻𝗶𝘀𝘁𝗮 𝗛𝗨𝗖𝗔, que este año celebra su primera edición virtual/on-line, donde el inglés será la lengua oficial. 📆28 y 29 de enero 2026 🕙09:00 a 17:00,…




Yup it is adenoid cystic carcinoma Check the histology and IHC bellow




Dear cyto friends, are cannonballs in pleural fluid a helpful clue? How? Please educate us! #pathology #cytopath

🫁 Lobectomy. 🔬 Lung Adenocarcinoma. Papillary Pattern. #LungPath #LungCancer.


1. Introducing a new thread: super basic lung pathology for PGY1s, with arrows. If you are a PGY1, leave a comment and I will tag you in a future post. A hamartoma is a disorganized mix of overgrown normal tissues (in their normal location) that creates a mass. Good news: they…

🦶🏽 Medical record: Acral Melanoma. 📏 Enlarged deep inguinal lymph node. 23mm. 💉 Ultrasound guided fine needle aspiration performed by Interventional Pathologist. 1️⃣ Pass. 25g. 🔬 Metastatic Melanoma. Category 5️⃣ The Sydney System. #FNAfriday #Cytology #CytoPath


I love Cytospin for some #HemePath #CytoPath scenarios and even more when #IHCPath results are so usefull. Small lymphocytic lymphoma. #IHCPath in the #CellBlock was also performed #FNAFriday

🗞 Segundo boletín de noticias #SEAPJoven 🍀 ¡¡75 becas de membresía de la @IACytology para los primeros 75 residentes en solicitarlas!! 🚨 Pídela en [email protected]

Felicitamos al Dr. Matías-Guiu @xmatiasguiu, Jefe de servicio de Anatomía Patológica del H.U. Arnau de Vilanova, Catedrático de la Universidad de Lleida e investigador del IRBLLEIDA, quien ha recibido el Premio Internacional Arnaldo Bruno en Roma, el pasado día 13 de Noviembre.

👦🏽 Young patient. 🐈 Animal contact. 📏 Submaxillary lymph node. 24mm. 💉 Ultrasound guided fine needle aspiration performed by Interventional Pathologist. 1️⃣ Pass. 25g. No anesthesia. 🔬 Non-necrotizing lymphadenitis. 🐾 Cat-scratch disease. #Cytology #CytoPath #Cytopathology


👩🎓 Este miércoles tenemos la V Jornada para estudiantes de Medicina de la SEAP 👩⚕️🔬 ¡Difúndelo entre tus estudiantes y no te la pierdas! #quieroserpatólogo #AnatomíaPatológica #Medstudent


An illustrative example of a pancreatic SPN. A picture says it all.🦎 #cytopath #SEAPJOVEN @IACytology @EfcsYoung @PapSociety @mtsiddi @CiolyRiveroC @MansoAso @RRobledano @samramed

United States Trends
- 1. Thanksgiving 2.3M posts
- 2. Lions 91.6K posts
- 3. Dan Campbell 6,539 posts
- 4. #GoPackGo 10.4K posts
- 5. Wicks 10.7K posts
- 6. Jordan Love 14.7K posts
- 7. Micah Parsons 9,837 posts
- 8. Goff 10.9K posts
- 9. Jack White 8,959 posts
- 10. McDuffie 2,723 posts
- 11. Watson 15.2K posts
- 12. #GBvsDET 4,666 posts
- 13. #ChiefsKingdom 3,191 posts
- 14. Caleb Wilson N/A
- 15. Jamo 5,066 posts
- 16. #OnePride 6,712 posts
- 17. Gibbs 8,766 posts
- 18. Turkey 292K posts
- 19. Thankful 471K posts
- 20. Matt LaFleur 2,736 posts
You might like
-
 Pembe Oltulu, MD
Pembe Oltulu, MD
@pembeoltulu -
 WC Faquin, MD, PhD
WC Faquin, MD, PhD
@bfaquin -
 Zubair Baloch
Zubair Baloch
@aakasharmand -
 Tania Labiano
Tania Labiano
@tlabiano -
 Vijay Shankar S
Vijay Shankar S
@VijayPatho -
 Matthew Cecchini MD PhD FRCPC
Matthew Cecchini MD PhD FRCPC
@Path_Matt -
 Eduardo Alcaraz, MD PhD
Eduardo Alcaraz, MD PhD
@edusqo -
 Laura G. Pastrián MD
Laura G. Pastrián MD
@DraEosina -
 Michael Arnold, MD, PhD
Michael Arnold, MD, PhD
@MArnold_PedPath -
 Irene Sansano, MD Phd
Irene Sansano, MD Phd
@SansanoValero -
 Xiaoyin "Sara" Jiang, MD (She/Her)
Xiaoyin "Sara" Jiang, MD (She/Her)
@Sara_Jiang -
 Vanda Torous MD
Vanda Torous MD
@VandaTorousMD -
 Sinchita Roy MD PhD
Sinchita Roy MD PhD
@Sinchita_Roy -
 Pascual Meseguer
Pascual Meseguer
@Histopatolomon -
 Stefania Landolfi
Stefania Landolfi
@steland011
Something went wrong.
Something went wrong.





















































































































































